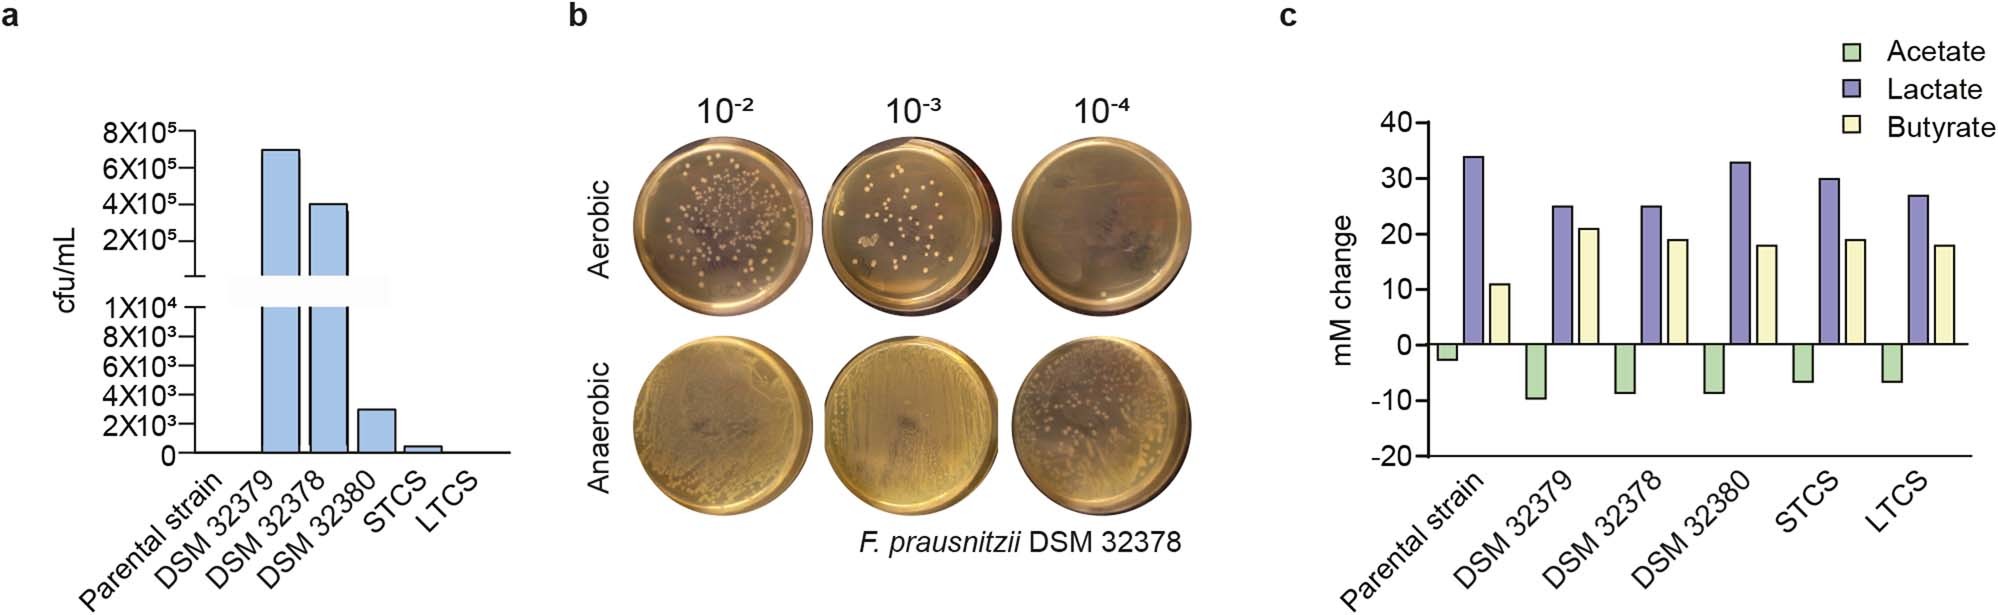
Extended Data Fig. 4

Extended Data Fig. 4: Oxygen tolerance and fermentation profiles of F. prausnitzii oxygen tolerant variants.
From: Synergy and oxygen adaptation for development of next-generation probiotics
a, Quantification of oxygen tolerance of parental strain and oxygen adapted variants in YCFAG. b, Oxygen tolerance of the oxygen adapted F. prausnitzii DSM 32378. Serial dilutions (shown on top) were inoculated on YCFAG plates and exposed to ambient air for 20 min, and compared with control plates incubated in anaerobiosis. c, Metabolite profile of parental DSM 32186 and oxygen adapted variants cultured in YCFAG medium. mM change on the y-axis indicates difference from inoculated medium at baseline.